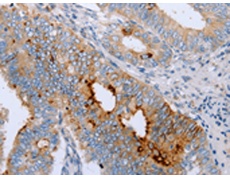
一抗

|
Background: |
Choline-specific glycerophosphodiester phosphodiesterase. Hydrolyzes lysophosphatidylcholine (LPC) to form monoacylglycerol and phosphorylcholine but not lysophosphatidic acid, showing it has a lysophospholipase C activity. Has a preference for LPC with short (12:0 and 14:0) or polyunsaturated (18:2 and 20:4) fatty acids. Also hydrolyzes glycerophosphorylcholine and sphingosylphosphorylcholine efficiently. Hydrolyzes the classical substrate for phospholipase C, p-nitrophenyl phosphorylcholine in vitro, while it does not hydrolyze the classical nucleotide phosphodiesterase substrate, p-nitrophenyl thymidine 5'-monophosphate. Does not hydrolyze diacyl phospholipids such as phosphatidylethanolamine, phosphatidylinositol, phosphatidylserine, phosphatidylglycerol and phosphatidic acid. |
|
Applications: |
ELISA, IHC |
|
Name of antibody: |
ENPP6 |
|
Immunogen: |
Fusion protein of human ENPP6 |
|
Full name: |
ectonucleotide pyrophosphatase/phosphodiesterase 6 |
|
Synonyms: |
NPP6 |
|
SwissProt: |
Q6UWR7 |
|
ELISA Recommended dilution: |
1000-2000 |
|
IHC positive control: |
Human cervical cancer |
|
IHC Recommend dilution: |
10-50 |

 購物車
購物車 幫助
幫助
 021-54845833/15800441009
021-54845833/15800441009